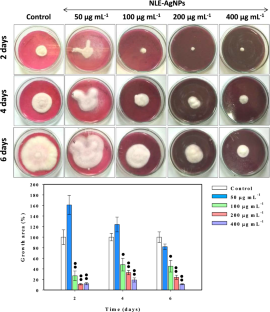

Abstract
This study was aimed at producing the eco-friendly, safe, and inexpensive silver (Ag) nanoparticles (NPs) and assessing its antimicrobial activity. Fungal pathogens isolated from diseased leaves and fruits of brinjal and bacterial pathogen obtained from a culture collection were used in this study. Green synthesis of AgNPs was performed and optimized using Azadirachta indica leaf extract. The newly synthesized AgNPs (λmax = 437 nm) showed isotropism in size (crystal size/diameter: 21/29 ± 5 nm) and morphology under transmission and scanning electron microscopy and energy dispersive X-ray analysis. The fourier transform infrared spectroscopy data suggested the role of various aliphatic/aromatic moieties and proteins in AgNPs stabilization. The AgNPs reduced the growth of Penicillium sp. maximally by 92% after 6 days. The sensitivity of test fungi towards AgNPs followed the order: Penicillium sp. (92%) > Fusarium sp. (89%) > Aspergillus sp. (69%). Exposure of Ralstonia solanacearum to AgNPs (MIC/MBC 200/400 µg ml−1) displayed damaged cellular envelopes, bulging of cells, and pit formation. The nucleic acid discharge showed a progressive increase from 8 to 34% (r2 = 0.97). The cellular metabolic activity and surface adhering ability of R. solanacearum were completely lost at 400 µgAgNPs ml−1. Results suggested that the AgNPs synthesized in this study had enough anti-pathogenic potential and could inexpensively and safely be used as a promising alternative to agrochemicals. Moreover, the findings observed in this study is likely to serve as an important indicator for the development of effective nano-control agents which in effect would help to manage some deadly phyto-pathogens capable of causing heavy losses to agricultural production systems.
Graphical Abstract
Effective inhibition of phytopathogenic microbes by eco-friendly neem leaf extract mediated silver nanoparticles (AgNPs)

Similar content being viewed by others
References
Katan J (2017) Diseases caused by soilborne pathogens: biology, management and challenges. J Plant Pathol 99:305–315. https://doi.org/10.4454/jpp.v99i2.3862
Shahid M, Zaidi A, Khan MS, Rizvi A, Saif S, Ahmed B (2017) Recent advances in management strategies of vegetable diseases. In: Microbial strategies for vegetable production, pp 197–226. https://doi.org/10.1007/978-3-319-54401-4_9
Al-Mughrabi KI, Vikram A, Poirier R, Jayasuriya K, Moreau G (2016) Management of common scab of potato in the field using biopesticides, fungicides, soil additives, or soil fumigants. Biocontrol Sci Technol 26:125–135. https://doi.org/10.1080/09583157.2015.1079809
Damalas CA, Eleftherohorinos IG (2011) Pesticide exposure, safety issues, and risk assessment indicators. Int J Environ Res Public Health 8:1402–1419. https://doi.org/10.3390/ijerph8051402
Shahid M, Ahmed B, Khan MS (2018) Evaluation of microbiological management strategy of herbicide toxicity to greengram plants. Biocatal Agric Biotechnol 14:96–108. https://doi.org/10.1016/j.bcab.2018.02.009
Shahid M, Ahmed B, Zaidi A, Khan MS (2018) Toxicity of fungicides to: pisum sativum: a study of oxidative damage, growth suppression, cellular death and morpho-anatomical changes. RSC Adv 8:38483–38498. https://doi.org/10.1039/c8ra03923b
Bahrami-Teimoori B, Nikparast Y, Hojatianfar M, Akhlaghi M, Ghorbani R, Pourianfar HR (2017) Characterisation and antifungal activity of silver nanoparticles biologically synthesised by Amaranthus retroflexus leaf extract. J Exp Nanosci 12:129–139. https://doi.org/10.1080/17458080.2017.1279355
Sandeep K, Lee J-K, Singh GP, Singh M, Bhatia SK, Kalia VC, Patel SKS (2019) Biotechnological application of polyhydroxyalkanoates and their composites as anti-microbials agents. In: Biotechnological applications of polyhydroxyalkanoates. Springer, Singapore, pp 207–225. https://doi.org/10.1007/978-981-13-3759-8_8
Otari SV, Pawar SH, Patel SKS, Singh RK, Kim SY, Lee JH, Zhang L, Lee JK (2017) Canna edulis leaf extract-mediated preparation of stabilized silver nanoparticles: characterization, antimicrobial activity, and toxicity studies. J Microbiol Biotechnol 27:731–738. https://doi.org/10.4014/jmb.1610.10019
Mahdizadeh V, Safaie N, Khelghatibana F (2015) Evaluation of antifungal activity of silver nanoparticles against some phytopathogenic fungi and Trichoderma harzianum. J Crop Prot 4:291–300
Ahmed B, Dwivedi S, Abdin MZ, Azam A, Al-Shaeri M, Khan MS, Saquib Q, Al-Khedhairy AA, Musarrat J (2017) Mitochondrial and chromosomal damage induced by oxidative stress in Zn2+ ions, ZnO-Bulk and ZnO-NPs treated Allium cepa roots. Sci Rep. https://doi.org/10.1038/srep40685
Kalia VC, Patel SKS, Kang YC, Lee JK (2019) Quorum sensing inhibitors as antipathogens: biotechnological applications. Biotechnol Adv 37:68–90. https://doi.org/10.1016/j.biotechadv.2018.11.006
Sonalkar MY, Nitave SA, Kagalkar AA (2014) Review on neem plant. World J Pharm Pharm Sci 3:590–598
Bindhani BK, Panigrahi AK (2014) Green synthesis of gold nanoparticles using neem (Azadirachta indica L.) leaf extract and its biomedical applications. Int J Adv Biotechnol Res 5:457–464
Elumalai K, Velmurugan S (2015) Green synthesis, characterization and antimicrobial activities of zinc oxide nanoparticles from the leaf extract of Azadirachta indica (L.). Appl Surf Sci 345:329–336. https://doi.org/10.1016/j.apsusc.2015.03.176
Solanki B, Khan MS, Ahmed B, Musarrat J, Zaidi A (2018) Bacterial toxicity of biomimetic green zinc oxide nanoantibiotic: insights into ZnONP uptake and nanocolloid–bacteria interface. Toxicol Res (Camb) 8:246–261. https://doi.org/10.1039/c8tx00267c
Ahmed B, Hashmi A, Khan MS, Musarrat J (2018) ROS mediated destruction of cell membrane, growth and biofilms of human bacterial pathogens by stable metallic AgNPs functionalized from bell pepper extract and quercetin. Adv Powder Technol 29:1601–1616. https://doi.org/10.1016/j.apt.2018.03.025
Ahmed B, Khan MS, Musarrat J (2018) Toxicity assessment of metal oxide nano-pollutants on tomato (Solanum lycopersicon): a study on growth dynamics and plant cell death. Environ Pollut 240:802–816. https://doi.org/10.1016/j.envpol.2018.05.015
Saleem S, Ahmed B, Khan MS, Al-Shaeri M, Musarrat J (2017) Inhibition of growth and biofilm formation of clinical bacterial isolates by NiO nanoparticles synthesized from Eucalyptus globulus plants. Microb Pathog 111:375–387. https://doi.org/10.1016/j.micpath.2017.09.019
Singh S, Singh BK, Yadav SM, Gupta AK (2015) Applications of nanotechnology in agricultural and their role in disease management. Res J Nanosci Nanotechnol 5:1–5. https://doi.org/10.3923/rjnn.2015.1.5
Patel SKS, Kim JH, Kalia VC, Lee JK (2019) Antimicrobial activity of amino-derivatized cationic polysaccharides. Indian J Microbiol 59:96–99. https://doi.org/10.1007/s12088-018-0764-7
Narayanan KB, Park HH (2014) Antifungal activity of silver nanoparticles synthesized using turnip leaf extract (Brassica rapa L.) against wood rotting pathogens. Eur J Plant Pathol 140:185–192. https://doi.org/10.1007/s10658-014-0399-4
Chen J, Li S, Luo J, Wang R, Ding W (2016) Enhancement of the antibacterial activity of silver nanoparticles against phytopathogenic bacterium Ralstonia solanacearum by stabilization. J Nanomater. https://doi.org/10.1155/2016/7135852
Azizian-Shermeh O, Einali A, Ghasemi A (2017) Rapid biologically one-step synthesis of stable bioactive silver nanoparticles using Osage orange (Maclura pomifera) leaf extract and their antimicrobial activities. Adv Powder Technol 28:3164–3171. https://doi.org/10.1016/j.apt.2017.10.001
Sasikala A, Linga Rao M, Savithramma N, Prasad TNVKV (2015) Synthesis of silver nanoparticles from stem bark of Cochlospermum religiosum (L.) Alston: an important medicinal plant and evaluation of their antimicrobial efficacy. Appl Nanosci 5:827–835. https://doi.org/10.1007/s13204-014-0380-8
Ahmed S, Ullah S, Ahmad M, Swami BL, Ikram S (2015) Green synthesis of silver nanoparticles using Azadirachta indica aqueous leaf extract. J Radiat Res Appl Sci 9:1–7. https://doi.org/10.1016/j.jrras.2015.06.006
Chahardoli A, Karimi N, Fattahi A (2018) Nigella arvensis leaf extract mediated green synthesis of silver nanoparticles: their characteristic properties and biological efficacy. Adv Powder Technol 29:202–210. https://doi.org/10.1016/j.apt.2017.11.003
He L, Liu Y, Mustapha A, Lin M (2011) Antifungal activity of zinc oxide nanoparticles against Botrytis cinerea and Penicillium expansum. Microbiol Res 166:207–215. https://doi.org/10.1016/j.micres.2010.03.003
Dakal TC, Kumar A, Majumdar RS, Yadav V (2016) Mechanistic basis of antimicrobial actions of silver nanoparticles. Front Microbiol. https://doi.org/10.3389/fmicb.2016.01831
Zhao Y, Zhang C, Chen H, Yuan M, Nipper R, Prakash CS, Zhuang W, He G (2016) QTL mapping for bacterial wilt resistance in peanut (Arachis hypogaea L.). Mol Breed 36:1–11. https://doi.org/10.1007/s11032-015-0432-0
Onodera A, Nishiumi F, Kakiguchi K, Tanaka A, Tanabe N, Honma A, Yayama K, Yoshioka Y, Nakahira K, Yonemura S, Yanagihara I, Tsutsumi Y, Kawai Y (2015) Short-term changes in intracellular ROS localisation after the silver nanoparticles exposure depending on particle size. Toxicol Rep 2:574–579. https://doi.org/10.1016/j.toxrep.2015.03.004
Acknowledgments
Mohammad Saghir Khan, Bilal Ahmed, and Javed Musarrat acknowledge the Council of Science and Technology, U.P., India for the financial support through the Research Grant #372. Mr. Pramod Kumar Sahu, Scientist, NBAIM, Mau, India is greatly acknowledged for providing the strain of R. solanacearum (NAIMCC-B-01626). The authors are also thankful for the support extended by University Sophisticated Instruments Facility (USIF), Aligarh Muslim University, Aligarh, India.
Author information
Authors and Affiliations
Corresponding author
Ethics declarations
Conflict of interest
The authors declare that there are no conflicts of interest.
Additional information
Publisher's Note
Springer Nature remains neutral with regard to jurisdictional claims in published maps and institutional affiliations.
Electronic Supplementary Material
Below is the link to the electronic supplementary material.
Rights and permissions
About this article
Cite this article
Haroon, M., Zaidi, A., Ahmed, B. et al. Effective Inhibition of Phytopathogenic Microbes by Eco-Friendly Leaf Extract Mediated Silver Nanoparticles (AgNPs). Indian J Microbiol 59, 273–287 (2019). https://doi.org/10.1007/s12088-019-00801-5
Received:
Accepted:
Published:
Issue Date:
DOI: https://doi.org/10.1007/s12088-019-00801-5




